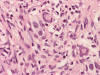
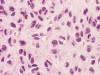
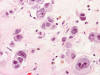

CT
Cytologic Smear
Cytolotic smear
Frozen
Frozen





S100
| A 65 year-old man with a Large Right Maxillary
Mass. July, 2020, Case 2007-1. Home Page |
Kar-Ming Fung, M.D., Ph.D. Last update: June 11, 2020.
Department of Pathology, University of Oklahoma Health Sciences Center, Oklahoma City, Oklahoma.
Clinical information: The patient was a 65 year-old man was referred to our institute because of a large mass in his right maxillary sinus with extension to the ethmoid sinus, and the orbit. A biopsy was performed. The patient was treated with radiaiton therapy and a hemi-maxillectomy with enucleation of the right globe was performed.
Radiology
of the Case:
There
was
large destructive mass
(Panel
A)
that
occupied
the bulk of the space of the right maxillary sinus with destruction of the floor
of the orbit and anterior wall of the maxillary sinus. Invasive fungal infection
could
generate this type of picture but the clinical story
did
not go along with it. A malignant tumor
was
the most likely diagnosis in this case.
The epicenter of the tumor did not seem to be of osseous origin. This made
osseous based tumors such as osteosarcoma and hematopoietic tumors such as
lymphoma and plasmacytoma less likely. With this type of growth pattern and the
location both taken into consideration, an epithelial neoplasm, most likely a
carcinoma, was the leading differential diagnosis.
Biopsy:
 |
 |
 |
 |
 |
|||
|
A. CT |
B. Cytologic Smear |
C. Cytolotic smear |
D. Frozen |
E. Frozen |
|||
 |
 |
 |
 |
 |
|||
| F. |
G. |
H. |
I. |
J. S100 |
Pathology of the biopsy:
An intra-operative consultation was performed. The cytologic preparation (Panel
B,
C)
yielded atypical cells with large nuclei with some of them having a small amount
of cytoplasm (Panel
B).
Frozen sections revealed a moderately cellular spindle cell tumor with some
intervening collagen fibers (Panel
D,
E).
There was no epithelial component. No prominent nucleoli were noted in either
preparation. A frozen section diagnosis of spindle cell neoplasm was made.
The permanent
section of the biopsy showed some variation in histopathologic picture. In some
areas, there were spindle cell proliferation (Panel
F,
G)
composed of cells with small nuclei and a moderate amount of cytoplasm. In a
minor proportion of areas, there were some clearing of cytoplasm with vague
epithelioid features. Some small nucleoli were present but there was no large,
prominent nucleoli nor pseudonuclear inclusion.
The leading
differential diagnoses based on histopathology was a sarcomatoid carcinoma
versus a sarcoma.
Immunohistochemistry of the biopsy:
MART-1, tyrosinase, HMB45,
beta-catenin, muscle specific actin, myogenin, desmin, CD34, CD3, CD20,
synaptophysin, cytokeratin AE1/AE3, cytokeratin 5/6, p63, calponin, &
glial fibrillary acidic protein (GFAP): Negative.
S100: Positive in some tumor cells.
(Panel
J)
Sox10: Positive in some tumor cells.
Microphthalmia transcription factor protein (MitF): Positive in a
small number of tumor cells.
Smooth muscle actin: Positive in many tumor cells.
Comment on the biopsy:
Both were not present in this case. The focal epithelioid changes can be
suggestive of a sarcomatoid carcinoma, melanoma, or sarcoma with focal
epithelioid change. The negative results for cytokeratins and the
histopathologic features did not provide a strong suggestion of a sarcomatoid
carcinoma although these tumor tend to lose epithelial markers often. The
positive immunoreactivity for S100 and Sox10 in addition to the spindle cell
neoplasm are suggestive of a malignant peripheral nerve sheath tumor (MPNST) and
melanoma. This tumor is negative for MART-1, tyrosinase, and HMB45 which does
not support a diagnosis of melanoma. The presence of a small number of MitF
positive cells suggested melanoma. However, MitF can be positive in a small
percentage (8%) of MPNST
[Gaspard
M et al., 2018].
S100 is often negative or totally lost in MPNST. The amount of S100
immunoreactivity was still moderately preserved. This finding was not in favor
of MPNST. The immunohistochemical profile was, therefore, in favor of melanoma
but MPNST could not be entirely ruled out.
Resection:
 |
|
 |
|
 |
|
 |
| K. | L. | M. | N. | O. | P. |
Q. Alcian blue |
 |
 |
 |
 |
 |
 |
|
| R. | S. |
T. Sox10 |
U. MitF |
V. MitF |
W. MitF |
Pathology of the
resected specimen:
The resected specimen is rather heterogeneous in histopathologic
changes. The minor part of the tumor was composed of high grade spindle
to epithelioid cells with large nuclei and a moderate to large amount of
cytoplasm. There was wide variation in nuclear sizes and pseudonuclear
inclusions were common (Panel
K,
L). The major part of this
tumor was composed of a chondroid neoplasm with a high (Panel
M,
N)
Immunohistochemistry of
the resected specimen: The dysplastic cells were positive for
Sox10 and MitF (Panel
T,
U). These cells suggested melanoma
in situ. Sox 10 and MitF were variably
positive (Panel
V) and negative (Panel
W) in the chondroid area. The
spindle cell areas also showed similar variation but the spindle cells were more
likely to be positive for both markers.
Molecular profile: No
mutation was detected by pyrosequencing in
BRAF V600E, K601E, or K601Q, IDH1
codon 132 or IDH2 codon 172.
Comment on pathology:
With the melanoma in situ identified,
the histopathologic features, and the immunohistochemical profile taken into
consideration, this tumor is best interpreted as a chondroid malignant melanoma.
The pseudonuclear inclusions, a feature of melanoma, is much more obvious in the
resection. The increase in pleomorphism and nuclear in the resected specimen may
be resulted from the radiation therapy.
Last, but not the least, one must acknowledge that the chondroid component was
not present in the biopsy material. Mutations in
IDH1 and
IDH2 are found in about 50% of the cases in chondrosarcoma. The lack
of mutations in these two genes does not entirely rule out a diagnosis of
chondrosarcoma but it does not support this diagnosis in this chondroid tumor.
| DIAGNOSIS: Chondroid melanoma (chondrosarcomatous melanoma). |
Discussion:
General Information
Pathology Immunohistochenistry
Molecular Pathology
Differential diagnosis
Related Cases
General Information:
Sinonasal cancer is uncommon with an overall incidence of 0.566 cases per 100,000 population per year with a male to female ration of 1.8:1. Almost 80% of these cases are seen in the nasal cavity (43.9%) and maxillary sinus (35.9%). Squamous cell carcinoma constitutes about half (51.6%) of all of the cases of sinonasal cancer. About 12.6% of sinonasal cancer are adenocarcinoma. Melanoma (6.6%), esthesioneuroblastoma (6.3%), and adenoid cystic carcinoma (6.2%) have comparable incidence. The rest are undifferentiated carcinoma (3.1%) and others (13.7%) [Turner JH and Reh DD, 2012].
Sinonasal melanoma occurs most commonly in the 7th
and 8th decade [Clifton
N et al., 2011;
Gandy I et al., 2006; ]. The incidence has increased steadily in
the past few decades [Turner
JH and Reh DD, 2012]. Most of them are seen in the nasal cavity and
maxillary sinus. Rare locations of primary sinonasal melanoma include the
sphenoid sinus [Busaba
NY, 2000;
Lynch SC et al., 2005]. Clinical presentations fall into three major
patterns- epistaxis, obstruction of airway, or effects of local compression and
destruction leading to cranial nerve paresis, visual impairment, headache, and
hypopituitarism. Sinonasal melanomas tend to be high on T1 signal partly due to
the presence of paramagnetic melanin and sometimes because of coexistent
hemorrhage. Melanotic tumors will be higher on T1 signal than amelanotic tumors
[Raghavan
P and Phillips CD, 2007]. The 5-year relative survival is poor with a
relative survival of 34.7 months [Turner
JH and Reh DD, 2012]. Pigmentation and pseudopapillary architectures
are two features associated with worse outcome in sinonasal melanoma
[Moreno
MA et al., 2010].
Pathology:
In addition to the classic variant of melanoma, there
are many unusual variants of melanoma [Benerjee
SS & Eyden B, 2008;
Magro C et al., 2006;
Cota C et al., 2019;
Saggini A et al., 2019]. These variants include angiomatoid melanoma,
“animal-type” melanoma (pigmented synthesizing melanoma, balloon cell melanoma
(sebocyte-like melanoma, pseudolipoblastic melanoma, melanoma with clear cells,
and granular cell melanoma), basosquamous melanoma (basomelanocytic tumor and
squamomelanocytic tumor), blue nevus-like melanoma and melanoma arising in blue
nevi (“malignant blue nevus”), bullous/acantolytic melanoma, carcinoid-like
melanoma, clear cell sarcoma, dermal melanoma, desmoplastic melanoma, follicular
melanoma, ganglioneuroblastic melanoma, “invisible” melanoma (epithelioid
melanoma in situ), lentiginous melanoma on the sundamaged skin of the elderly,
lichenoid keratosis-like melanoma, melanoma resembling MPNST, melanoma with
aberrant immunophenotype, micromelanoma, monster cell melanoma, multinucleated
cell melanoma, myxoid melanoma, nested melanoma of the elderly, neurotrophic
melanoma and melanoma with neural differentiation, nevoid melanoma,
osteo-cartilagineous melanoma, pigmented epithelioid melanocytoma, plasmacytoid
melanoma, plexiformmelanoma (deep penetrating nevus-like melanoma), polypoid
melanoma, pseudoglandular melanoma, regressing melanoma (melanoma with complete
regression), rhabdoid melanoma, sarcomatoid melanoma, signet ring cell melanoma,
small cell melanoma, spindle cell melanoma, syringotrophic melanoma, verrucous
melanoma and melanoma with pseudoepitheliomatous hyperplasia, and others.
Now we can see that melanoma can mimic a variety of
entities that span from plasmacytoma (plasmacytoid melanoma) to adenocarcinoma
(signet ring cell melanoma, pseudoglandular melanoma) to clear cell carcinoma
(balloon cell melanoma) to verrucous carcinoma (verrucous melanoma and melanoma
with pseudoepitheliomatous hyperplasia) to squamous cell carcinoma (basosquamous
melanoma) to spindle cell tumor (desmoplastic sarcoma and sarcomatoid melanoma).
In order not to fall into these diagnostic pitfalls, one must remember that many
melanomas are amelanomatic. If the melanin pigment is present, it would be a big
help but the chance is that they are not there. So, being familiar with these
variants and a high index of suspicion is the best way to avoid these pitfalls.
Osteo-cartilagineous melanoma (also known as
chondrosarcomatous and osteosarcomatous melanoma)
[Ali
AM et al., 2018] contains component with osseous or cartilagineous
metaplasia in pure or mixed form [Benerjee
SS & Eyden B, 2008;
Lucas DR et al., 1993;
Devesa PJ et al., 2013]. This variant is more common on acral skin
[Sweeney
SP & Royer MC, 2020;
Emanuel PO et al., 2007], subuncal region
[Devesa
PJ et al., 2013;
Pisano C et al., 2020; ], and in mucosal melanomas
[Sweeney
SP & Royer MC, 2020;
Ackley CD et al., 2001;
Ali AM et al., 2018;
Benerjee SS & Eyden B, 2008;
Hoorweg JJ et al., 1997]. Melanomas with only chondroma and devoided
of osseous component are rare and only 21 cases have been reported
[Sweeney
SP & Royer MC, 2020]. Many of these cases are associated with a
history of recurrent trauma or previous surgery suggesting that chronic
reparative process may contribute to the production of chondroid component
[Murali
R et al., 2010;
Piana S et al., 2009;
Rinaggio J et al., 2008;
Banerjee SS et al., 1998;
Grunwald MH et al, 1985].
In some cases, osseous and chondroid metaplasia are noted in the metastasis
[Piana
S et al., 2009;
Grunwald MH et al, 1985;
McKay KM et al., 2012;
Hoorweg JJ et al., 1997]. This suggest that the change in
microenvironment may be responsible for triggering the metaplastic changes.
In general, the osteo-cartilagineous component usually
makes up only a small part of the tumor [Saggini
A et al., 2019]. The current case defied this general rule.
Recognition of in situ melanoma, areas
with pagetoid spread, or areas with classic features of melanoma would provide
important diagnostic clue. With these features considered, misdiagnosis do not
happen often [McKay
KM et al., 2012;
Emanuel PO et al., 2007].
Immunohistochemistry and molecular pathology can provide
further characterization of these cases. Markers such as MART-1, tyroinase,
HMB45, Sox10, and S100 can be used to reveal the melanocytic nature of these
tumors. It is important to remember that melanoma specific markers can be
negative at least focally in the osseous and chondroid component as illustrated
in this case.
It is equally important to know that that the chondroid
and osseous component can be positive for Sox9 and STAB2 which are two markers
that have specificity for chondroid and osseous differentiation
[Ali
AM et al., 2018;
McKay KM et al., 2012]. These marker can be used to recognize the
chondroid and osseous differentiation but it cannot be used to identify the
underlying melanoma.
Molecular Pathology:
Very little data is available for melanoma with
chondroid metaplasia. In one case, an NRAS Q61 mutation was detected
[Sweeney
SP & Royer MC, 2020].
Differential Diagnosis:
Diagnosis of osteo-cartilagineous melanoma can be
challenging particularly with small biopsy. When a small biopsy contains
exclusively of the osseous or chondroid component, the histopathologic features
will suggest osteosarcoma and chondrosarcoma. In detail search of areas that are
histologically classic for in situ or
invasive melanoma is the first step and this case serves as a great example.
Sarcoma and
sarcomatoid carcinoma in general: A high index of suspicion is very
important. One must remember that epithelial neoplasm is far more common than
melanoma which, in turn, is more common than sarcoma in a mucosa lined anatomic
structure such as the areodigestive tract. Besides, osteo-cartilagineous
metaplasia may also occur in carcinoma [Wargotz
ES & Norris HJ, 1997;
Ikoma S et al., 2017;
Marioni G et al., 2004;
Yokoo H et al., 1999]. The
first step, therefore, is to rule out sarcomatoid and metaplastic carcinoma or
melanoma. In contrast, genuine extraskeletal chondrosarcoma and osteosarcoma
other than mesenchymal chondrosarcoma extremely uncommon to present as a mucosal
or soft tissue based mass. Also, the extent of osseous and chondroid metaplasia
only represent a small volume of the tumor in most cases. So, a detail
examination of the non-osseous, non-chondroid area would provide good help.
Immunohistocheistry for epithelial markers and melanoma can be used to reveal
the nature of these tumors.
Apocrine
chondroid syringoma (apocrine mixed tumor): This is an uncommon cutaneous
tumor that occurs in the head and neck region of middle-aged and elderly
patients. Extremities are uncommon sites. Histologically, it has a myxoid,
chondroid, and fibrous stroma populated by an epithelial component with cells
arranged I clusdes, cords, and ductal structure. Other than the chondroid
matrix, it has very little resemblance with chondroid melanoma.
Mesenchymal
chondrosarcoma: This tumor is characterized by cartilaginous islands
surrounded by highly cellular sarcomatous component. It has a high incidence to
occur as an extraskeletal tumor and often occurs in the head and neck region.
These tumor are negative for MART-1 and HMB45.
IRF2BP2-CDX1 fusion was demonstrated
in 10 of 15 cases of mesenchymal chondrosarcomas
[Nyquist
KB et al., 2012]
which can be used as a diagnostic aid.
Related Cases: